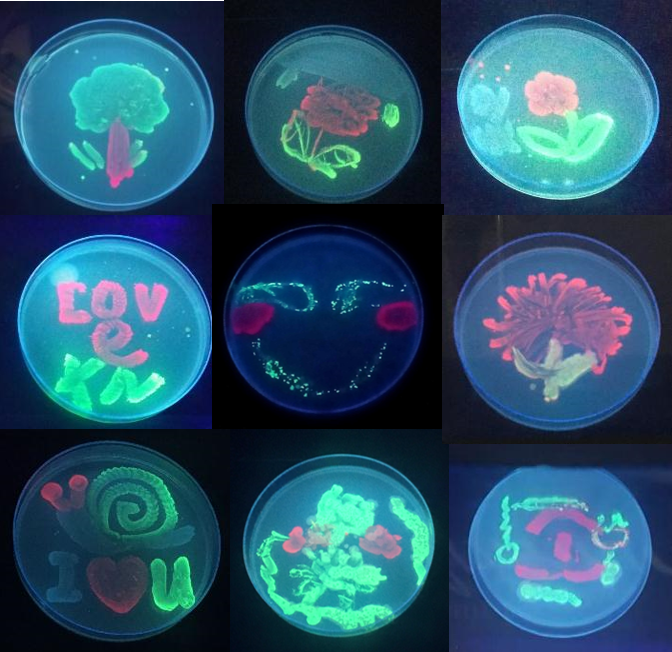

在快乐的学习中,充分发挥自己的创意,利用表达不同荧光蛋白的细菌绘出了绚丽多彩的画面,表达自己内心纯净多彩的世界,大家都来感受下微生物形成的美丽图案吧。
这是生命开元生物工程系开设的面向全校的生命科学基础I课程实验结果。随着生命科学的发展以及人们对生存、能源、环境等全球问题重要性的认识,国内外一些著名的综合性或理工科院校纷纷对非生物专业学生增开或强化了以生命科学基础为核心的教学内容。为强调数理化生的战略必争地位,生命开元生物工程系开设此课程,旨在对理工科学生普及并强化生物学知识。
2016年,生命科学基础I首先在自动化、钱学森以及物理三个专业中试点开设。配合44学时的理论课,生物系开设了8学时的“生物大分子结构模拟”和“PCR技术鉴定人类性别”两个内容的实验课程。学生对此展现了极高的兴趣,实验结束后的调查问卷发现,学生期待有机会接触更多有趣、前沿的生物学实验。
基于此,2017年该课程开始对全校十个专业开放,同时增加了 “荧光蛋白的表达与微生物绘画点亮微观世界”的实验内容,让同学们在掌握荧光蛋白基本光学原理及有关生物大分子相关知识的基础上,熟悉荧光蛋白在生物体内的表达过程;通过表达不同颜色荧光蛋白的微生物的培养,创作微生物绘画,了解微生物培养方法,学习生物分子荧光现象及其应用。
通过此类实验,同学们用自己的双手将由于肉眼不可见而显得高深莫测的微观世界点亮起来,直观感受生命科学的奇妙,激发了学生热爱生命、探索生命世界的热情,感知到生命科学非但高深,而且趣味十足。
